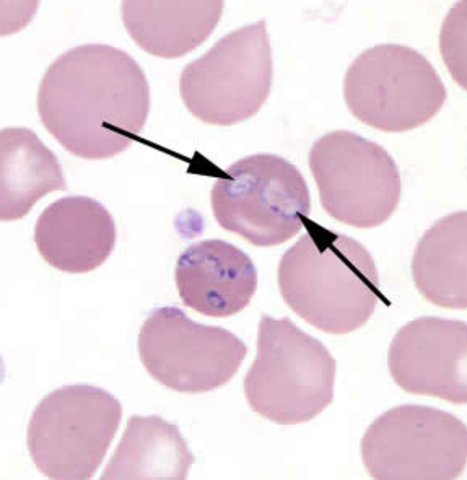
SUSPECT!!!

-
A tick bites Skin, the outer skirts of the cities, and it goes almost unnoticed. The tick was identified as an Ixodes scapularis tick.
-
A few days later, the body starts showing cold and flu symptoms such as nausea, chills, drenching sweat, and body aches. In the city, the temperature rises throughout the day.
-
The suspect, Babesia Microti was witnessed attack red blood cells on duty.
-
After a day of investigation, the problem has been diagnosed as babesiosis. It is common in the United States, and can be caused by blood transfusions sometimes, but is mostly transmitted through ticks.
-
Once the word is sent out, sporozoites are released into Plasma Central for a little bit. Then the immunoglobulin G antibodies can stop infection by binding and neutralizing sporozoites before they can destroy and invade any more cells
-
In order to help the problem at hand, the Quinine and Clinamyacin Duo will be assisting for about 7-10 days.
-
In order to prevent this event from occuring again, the body will be avoiding any areas with ticks, especially during warm months. Also, avoiding contact with vegetation would be ideal. Wearing long clothing and shoes that cover your feet will also be considered.
Both the body and any owned pets should be checked for ticks often.
Want to make a timeline like this?
Use Timetoast to turn dates, events, milestones, and phases into a clear visual timeline you can build and share. Timetoast is a timeline maker for work, school, research, and stories.